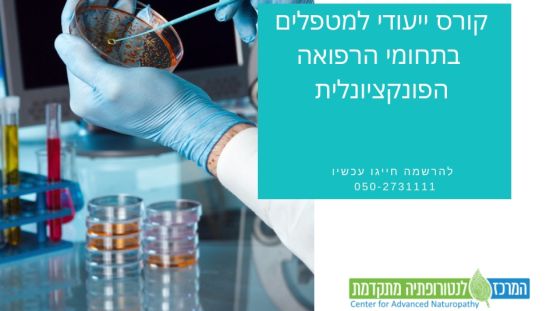

המסע אל רפואת העתיד - רפואה פונקציונלית

מאת: רון יפה – המרכז לנטורופתיה מתקדמת
- רון יפה הינו מומחה לטיפול פונקציונלי ונטורופתיה
קורס ייחודי ובלעדי להכשרה מעשית לעבודה וטיפול עבור קהל המטפלים, הרופאים והעוסקים בתחום הרפואה המשלימה. הקורס היחיד בישראל המקיף את כל מעגלי הטיפול בעולם רפואת המחר-הפונקציונלית, ומעניק למשתתפי הקורס הבנה, ידע תיאורטי, כלים פרקטיים ,היכרות והתמקצעות בטיפול בפציינטים בעלי בעיות רפואיות ללא מענה ופתרונות הרפואה בישראל, ושילובם חזרה למעגל הבריאות ותפקוד יומיומי תקין.
מיקום ושעות לימוד: 30 מפגשים של 4 שעות כל מפגש
השיעורים יערכו ברעננה, בימי שני החל ממועד ה-1.4.19 בין השעות 17:30-21:0 אחת לשבוע.חניה חופשית!
לימודים בסיסיים קודמים:
אנטומיה, פיזיולוגיה ופתולוגיה
מטרות הקורס:
להכשיר מטפלים ברפואה פונקציונלית
צרו קשר עם רון יפה – המרכז לנטורופתיה מתקדמת











